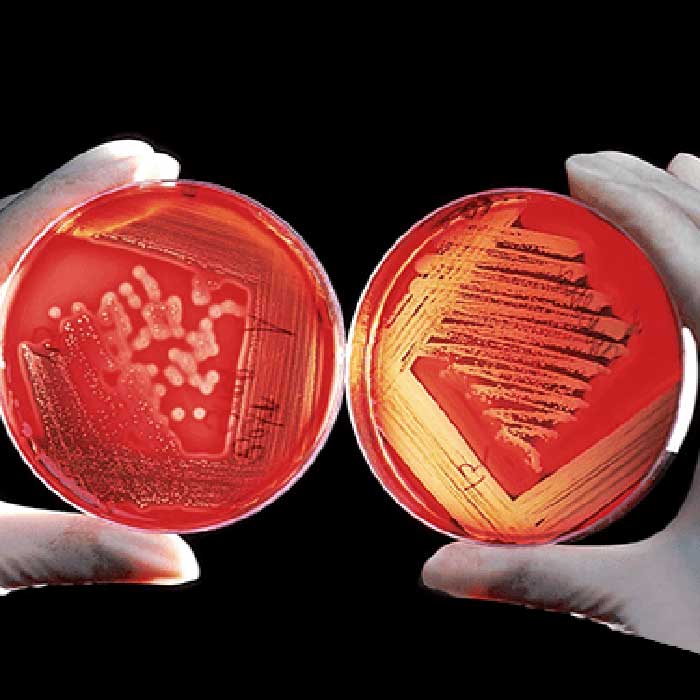

Lactic acid bacteria in food products – part II
Jak opisano w pierwszej części artykułu, bakterie fermentacji mlekowej są szeroko wykorzystywane w przemyśle spożywczym. Ich wielokierunkowe zastosowanie wynika nie tylko z ich funkcji ściśle technologicznych, ale także udokumentowanych właściwości prozdrowotnych. Przemysł mleczarski Przemysł mleczarski w największym stopniu wykorzystuje potencjał bakterii fermentacji mlekowej. Także wśród konsumentów, wyroby tego typu cieszą się dużą popularnością tym bardziej, […]
Bakterie fermentacji mlekowej w produktach spożywczych – cz. II
Jak opisano w pierwszej części artykułu, bakterie fermentacji mlekowej są szeroko wykorzystywane w przemyśle spożywczym. Ich wielokierunkowe zastosowanie wynika nie tylko z ich funkcji ściśle technologicznych, ale także udokumentowanych właściwości prozdrowotnych. Przemysł mleczarski Przemysł mleczarski w największym stopniu wykorzystuje potencjał bakterii fermentacji mlekowej. Także wśród konsumentów, wyroby tego typu cieszą się dużą popularnością tym bardziej, […]